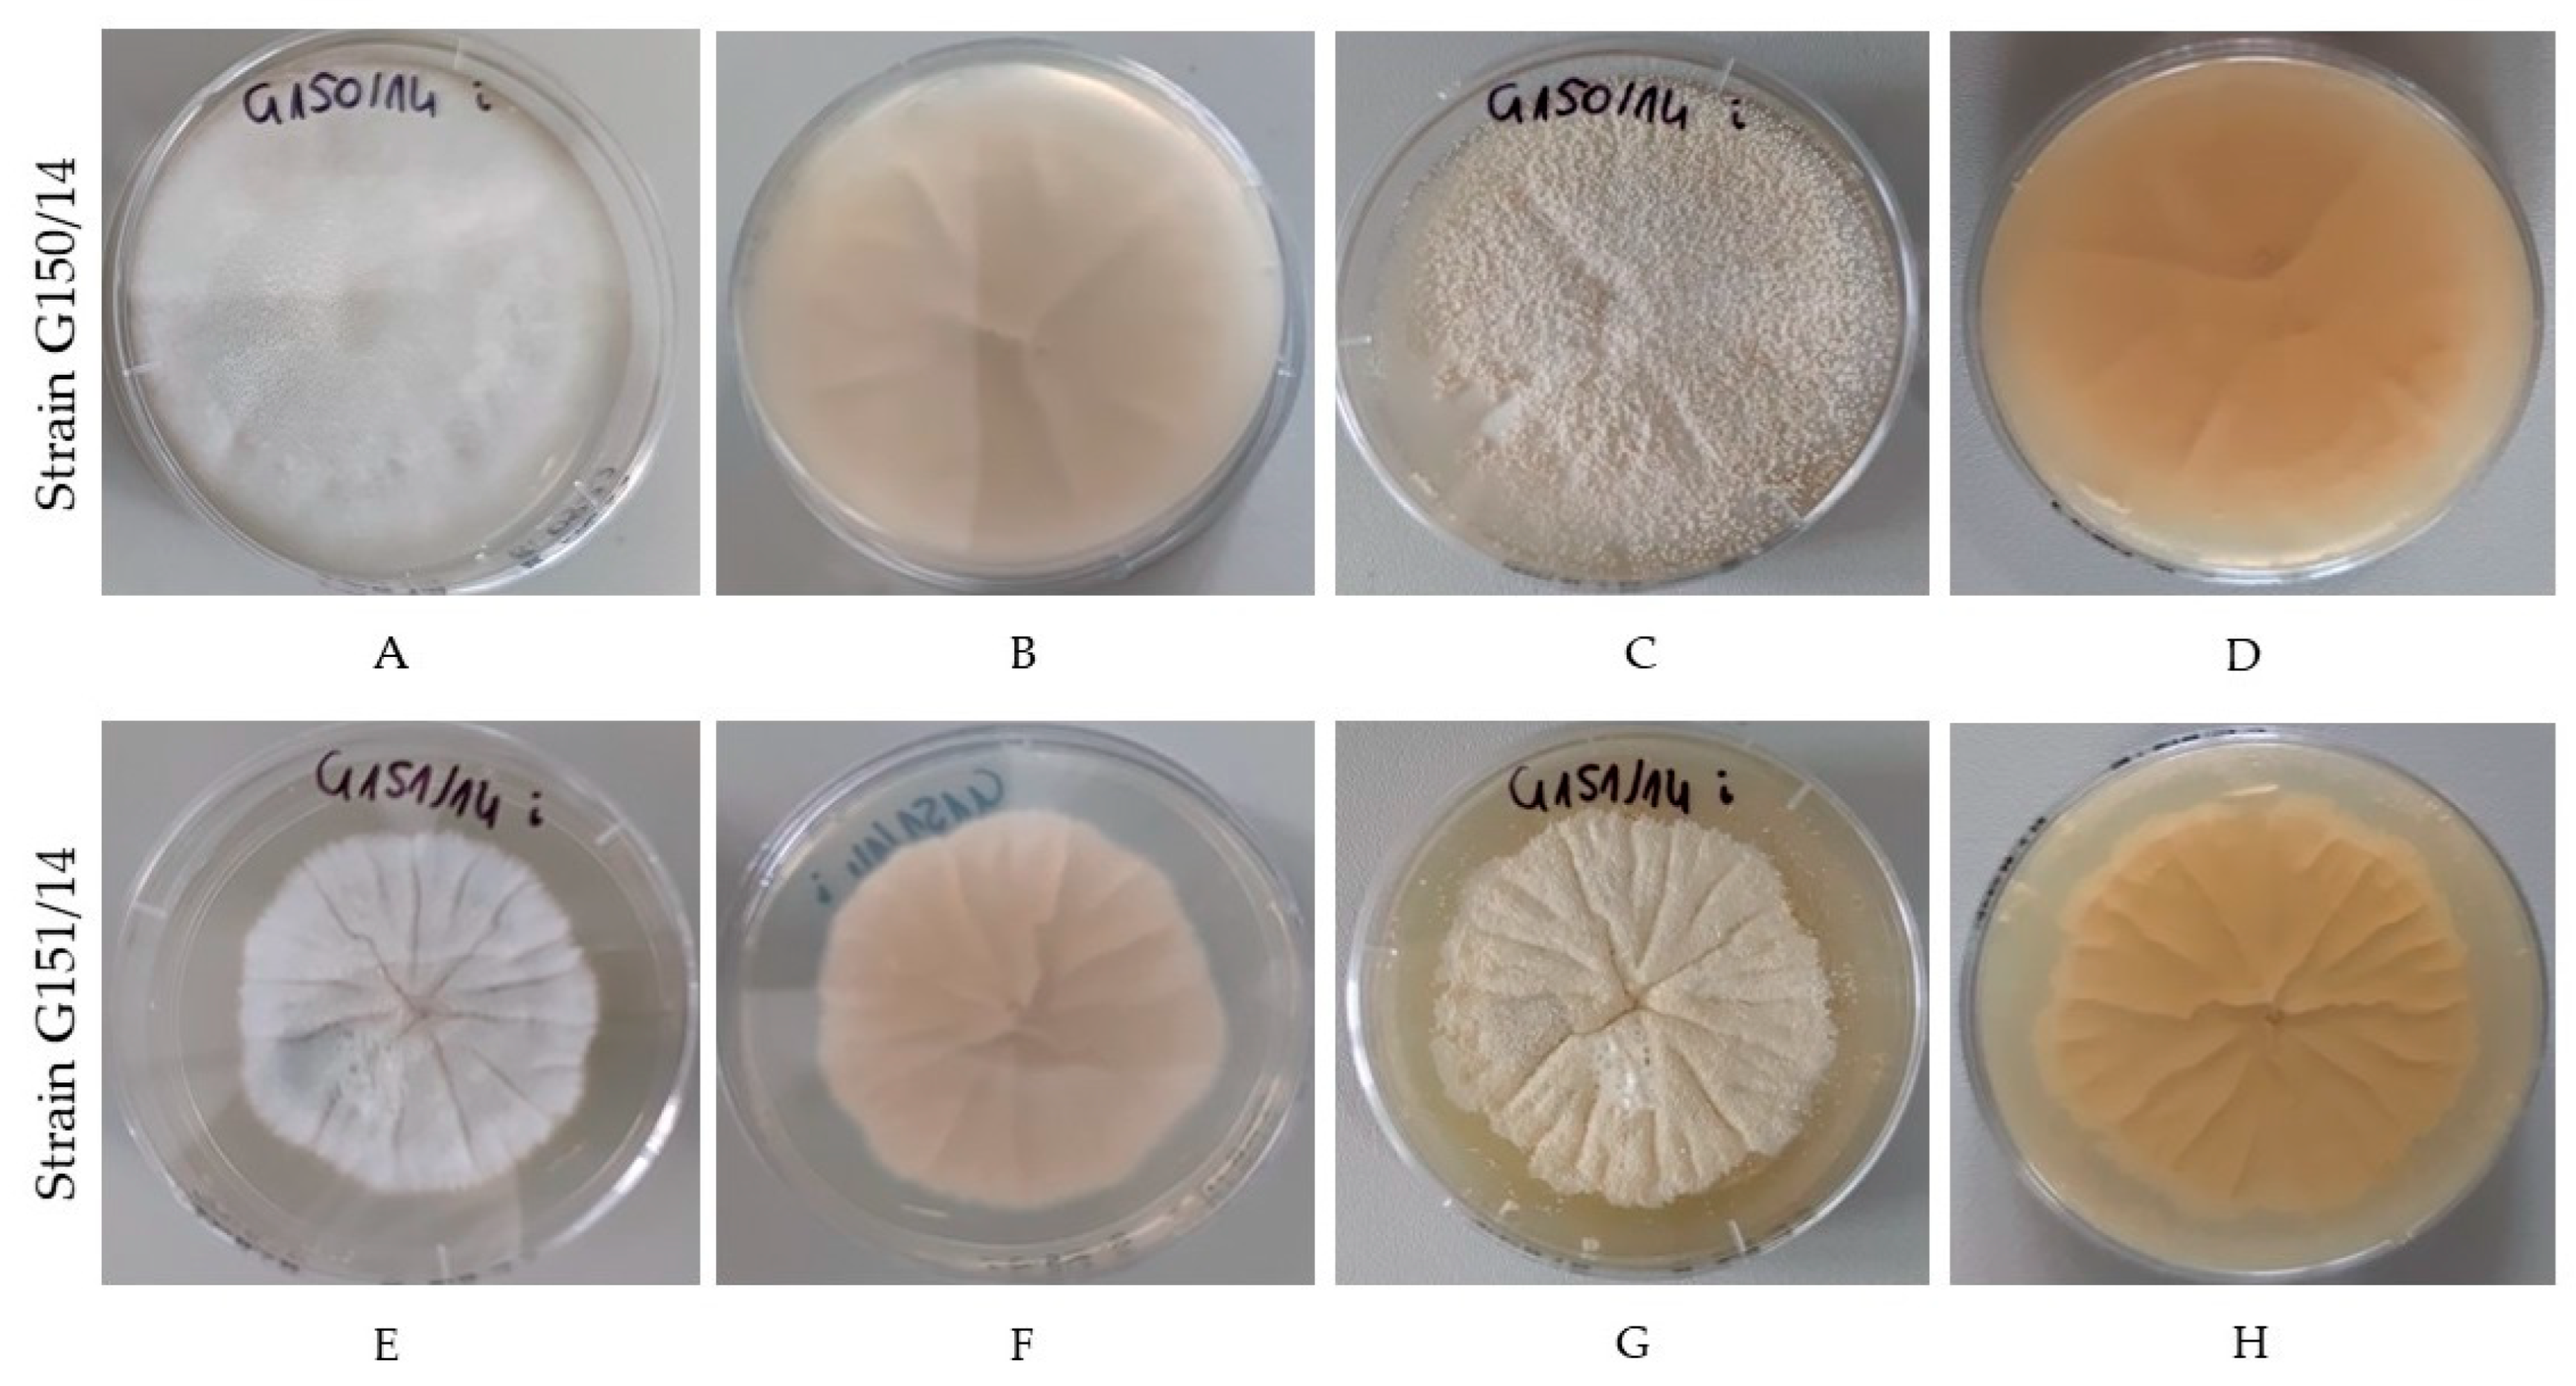
Ijms 24 01543 g002 Ijms 24 01543 g002

Soil-Borne Neosartorya spp.: A Heat-Resistant Fungal Threat to Horticulture and Food Production—An Important Component of the Root-Associated Microbial Community
Abstract
1. Introduction
2. Characteristic of Neosartorya spp.
3. Biodiversity of Neosartorya spp.
| Name | Telomorph | Relation to Other Species | Key Characteristics | Type of Growth | Reference | 
|---|---|---|---|---|---|
| N. spinosa | Aspergillus fischeri var. spinosus | Has identical partial beta-tubulin and calmodulin gene sequences to N. botucatensis and N. paulistensis | Rough ascospores | On MEA: broad growth in pale yellow or yellowish white colour; thin layer of mycelium and abundant, granular cleistothecia | [12,26,27] | 
| N. laciniosa | Aspergillus laciniosus | Closely related to N. coreana | Microtuberculate ascospores with two bent crests and two distinct equatorial rings of small projections | On MAA: beige with light yellow ascospores; on CYA: light yellow and white growth | [12,22,26] | 
| N. glabra | Aspergillus fischeri var. Glaber | Extrolites typical for N. fennelliae, but is more closely related to N. denticulate, despite having divergent ornamentations of ascospores | Confirmed to be a disease agent; homothallic species | Yellow–white to pale yellow cleistothecia, smooth ascospores | [12,22,28] | 
| N. assulata | Aspergillus assulatus | Closely related to A. waksmanii with only 2% bp difference in the act1 locus | Common extrolites produced by its colonies are indole alkaloids and apolar metabolites | Snow-white growth on MEA medium | [22,29] | 
4. Two Sides of the Same Coin
5. Heat Response in Neosartorya spp. Fungi
5.1. Impact of the Environment
5.2. Heat Shock Proteins—HSPs
5.3. Trehalose and Mannitol
5.4. Other Metabolites
6. Interactions between Neosartorya and Plants
7. Fruit and Vegetable Production in the European Union
7.1. Organic Crop Production
7.2. Poland as a Leader in Fruit Production in the European Union
7.3. European Union Policy Framework
7.4. Common Problems in Fruit Production
7.5. Methods of Postharvest Food Preservation
8. Conclusions and Future Directions
Author Contributions
Funding
Institutional Review Board Statement
Informed Consent Statement
Data Availability Statement
Conflicts of Interest
References
- Gomiero, T.; Pimentel, D.; Paoletti, M.G. Environmental Impact of Different Agricultural Management Practices: Conventional vs. Organic Agriculture. CRC Crit. Rev. Plant Sci. 2011, 30, 95–124. [Google Scholar] [CrossRef]
 - Igras, J.; Pokojski, Z.; Kowalski, A.; Krasowicz, S.; Labetowicz, J.; Matyka, M.; Wijaszka, T. 25 Years of Polish Agriculture Food Security in Europe; Conference Centre: Puławy, Poland, 2014; p. 75. (In Polish) [Google Scholar]
 - Frąc, M.; Jezierska-Tys, S.; Yaguchi, T. Occurrence, Detection, and Molecular and Metabolic Characterization of Heat-Resistant Fungi in Soils and Plants and Their Risk to Human Health. Adv. Agron. 2015, 132, 161–204. [Google Scholar]
 - European Commission. Communication from the Commission to the European Parliament, the Council, the European Economic and Social Committee and the Committee of the Regions; A Farm to Fork Strategy for a Fair, Healthy and Environmentally-friendly Food System; European Commission: Brussels, Belgium, 2020; ISBN 9789896540821. [Google Scholar]
 - Panek, J.; Frąc, M.; Bilińska-Wielgus, N. Comparison of Chemical Sensitivity of Fresh and Long-Stored Heat Resistant Neosartorya fischeri Environmental Isolates Using BIOLOG Phenotype MicroArray System. PLoS ONE 2016, 11, e0147605. [Google Scholar] [CrossRef]
 - Li, S.; Smith, K.D.; Davis, J.H.; Gordon, P.B.; Breaker, R.R.; Strobel, S.A. Eukaryotic resistance to fluoride toxicity mediated by a widespread family of fluoride export proteins. Proc. Natl. Acad. Sci. USA 2013, 110, 19018–19023. [Google Scholar] [CrossRef] [PubMed]
 - Kikoku, Y.; Tagashira, N.; Gabriel, A.A.; Nakano, H. Heat activation of Neosartorya and Talaromyces ascospores and enhancement by organic acids. Biol. Sci. 2009, 14, 87–95. [Google Scholar] [CrossRef]
 - Chipley, J.R. Sodium benzoate and benzoic acid. In Antimicrobials in Food, 3rd ed.; Davidson, P.M., Sofos, J.N., Branen, A.L., Eds.; CRC Press: Boca Raton, FL, USA; Taylor & Francis: Abingdon, UK, 2005; Volume 145, pp. 11–48. [Google Scholar]
 - Nielsen, P.V. Preservative and Temperature Effect on Growth of Three Varieties of the Heat-Resistant Mold, Neosartorya fischeri, as Measured by an Impedimetric Method. J. Food Sci. 1991, 56, 1735–1740. [Google Scholar] [CrossRef]
 - Bromley, M.J.; van Muijlwijk, G.; Fraczek, M.G.; Robson, G.; Verweij, P.E.; Denning, D.W.; Bowyer, P. Occurrence of azole resistant species of Aspergillus in the UK environment. J. Glob. Antimicrob. Resist. 2014, 2, 276–279. [Google Scholar] [CrossRef]
 - Delgado, D.A.; Sant’Ana, A.S.; Granato, D.; Massaguer, P.R. Inactivation of Neosartorya fischeri and Paecilomyces variotii on paperboard packing material by hydrogen peroxide and heat. Food Control 2012, 23, 165–170. [Google Scholar] [CrossRef]
 - Hong, S.B.; Cho, H.S.; Shin, H.D.; Frisvad, J.C.; Samson, R.A. Novel Neosartorya species isolated from soil in Korea. Int. J. Syst. Evol. Microbiol. 2006, 56 Pt 2, 477–486. [Google Scholar] [CrossRef]
 - De Cássia, M.S.B. Chapter 16—Pathogens and Spoilage Microorganisms in Fruit Juice: An Overview. In Fruit Juices; Academic Press: San Diego, CA, USA, 2018; pp. 291–308. [Google Scholar]
 - Pitt, J.I.; Hocking, A.D. Fungi and Food Spolage. J. Chem. Inf. Model. 2013, 53, 1689–1699. [Google Scholar]
 - Wyatt, T.T.; Wösten, H.; Dijksterhuis, J. Fungal spores for dispersion in space and time. Adv. Appl. Microbiol. 2013, 85, 42–91. [Google Scholar]
 - Dyer, P.S.; Paoletti, M. Reproduction in Aspergillus fumigatus: Sexuality in a supposedly asexual species? Med. Mycol. 2005, 43 (Suppl. 1), S7–S14. [Google Scholar] [CrossRef]
 - Kwon-Chung, K.J.; Sugui, J. Sexual Life Cycle of Aspergillus fumigatus. Korean J. Med. Mycol. 2011, 16, 81–85. [Google Scholar]
 - Hong, S.-B.; Shin, H.-D.; Hong, J.; Frisvad, J.C.; Nielsen, P.V.; Varga, J.; Samson, R.A. New taxa of Neosartorya and Aspergillus in Aspergillus section Fumigati. Int. J. Gen. Mol. Microbiol. 2008, 93, 87–98. [Google Scholar] [CrossRef] [PubMed]
 - Rydholm, C.; Szakacs, G.; Lutzoni, F. Low Genetic Variation and No Detectable Population Structure in Aspergillus fumigatus Compared to Closely Related Neosartorya Species. Eukaryot. Cell 2006, 5, 650–657. [Google Scholar] [CrossRef] [PubMed]
 - Balajee, S.A.; Gribskov, J.; Brandt, M.; Ito, J.; Fothergill, A.; Marr, K.A. Mistaken Identity: Neosartorya pseudofischeri and Its Ana-morph Masquerading as Aspergillus fumigatus. J. Clin. Microbiol. 2005, 43, 5996–5999. [Google Scholar] [CrossRef]
 - Takada, M.; Horie, Y.; Abliz, P. Two new heterothallic Neosartorya from African soil. Mycoscience 2001, 42, 361–367. [Google Scholar] [CrossRef]
 - Samson, R.A.; Hong, S.; Peterson, S.W.; Frisvad, J.C.; Varga, J. Polyphasic taxonomy of Aspergillus section Fumigati and its teleo-morph Neosartorya. Stud. Mycol. 2007, 59, 147–203. [Google Scholar] [CrossRef]
 - Yaguchi, T.; ImanishiI, Y.; Matsuzawa, T.; Hosoya, K.; Hitomi, J.; Nakayama, M. Method for Identifying Heat-Resistant Fungi of the Genus Neosartorya. J. Food Prot. 2012, 75, 1806–1813. [Google Scholar] [CrossRef] [PubMed]
 - Souza-Motta, C.M.; Cavalcanti, M.A.Q.; Porto, A.L.F.; Moreira, K.A.; Lima Filho, J.L. Aspegillus niveus Blochwitz 4128URM: New source for inulinase production. Braz. Arch. Biol. Technol. 2005, 48, 343–350. [Google Scholar] [CrossRef]
 - Prigitano, A.; Esposto, M.C.; Carnevali, D.; Catena, E.; Auxilia, F.; Castaldi, S.; Romanò, L. Neosartorya hiratsukae: Environmental isolation from intensive care units in an Italian hospital. Infect. Control. Hosp. Epidemiol. 2021, 43, 949–950. [Google Scholar] [CrossRef]
 - Samson, R.A.; Hong, S.B.; Frisvad, J.C. Old and new concepts of species differentiation in Aspergillus. Med. Mycol. 2006, 44 (Suppl. 1), 133–148. [Google Scholar] [CrossRef] [PubMed]
 - DesDesagiacomo, C.C.V.; Alnoch, R.C.; Pinheiro, V.E.; Cereia, M.; Machado, C.B.; Damasio, A.; Augusto, M.J.; Pedersoli, W.; Silva, R.N.; Polizeli, M.D.L.T.D.M. Structural model and functional properties of an exo-polygalacturonase from Neosartorya glabra. Int. J. Biol. Macromol. 2021, 186, 909–918. [Google Scholar] [CrossRef]
 - Horie, Y.; Miyaji, M.; Nishimura, K.; Franco, M.F.; Coelho, K.I.R. Two new species of Neosartorya from Brazilian soil. Mycoscience 1995, 36, 159–165. [Google Scholar] [CrossRef]
 - Hubka, V.; Peterson, S.W.; Frisvad, J.C.; Yaguchi, T.; Kubátová, A.; Kolařík, M. Aspergillus waksmanii sp. nov. and Aspergillus marvanovae sp. nov., two closely related species in section Fumigati. Int. J. Syst. Evol. Microbiol. 2013, 63 Pt 2, 783–789. [Google Scholar] [CrossRef]
 - dos Santos, J.L.P.; Membré, J.-M.; Jacxsens, L.; Samapundo, S.; Van Impe, J.; Sant’Ana, A.S.; Devlieghere, F. Quantitative microbial spoilage risk assessment (QMSRA) of pasteurized strawberry purees by Aspergillus fischeri (teleomorph Neosartorya fischeri). Int. J. Food Microbiol. 2020, 333, 108781. [Google Scholar] [CrossRef]
 - Liang, W.-L.; Le, X.; Taglialatela-Scafati, O.; Yang, X.; Chen, J.-X.; Xu, J.; Liu, H.-L.; Wang, L.-Y.; Wang, K.-T.; Hu, K.-C.; et al. Exploring the chemodiversity and biological activities of the secondary metabolites from the marine fungus Neosartorya pseudofischeri. Mar. Drugs 2014, 12, 5657–5676. [Google Scholar] [CrossRef]
 - Fornal, E.; Parfieniuk, E.; Czeczko, R.; Bilinska-Wielgus, N.; Frąc, M. Fast and easy liquid chromatography—Mass spectrometry method for evaluation of postharvest fruit safety by determination of mycotoxins: Fumitremorgin C and verruculogen. Postharvest Biol. Technol. 2017, 131, 46–54. [Google Scholar] [CrossRef]
 - Van Egmond, H.; Schothorst, R.; Jonker, M. Regulations relating to mycotoxins in food. Anal. Bioanal. Chem. 2007, 389, 147–157. [Google Scholar] [CrossRef] [PubMed]
 - Van Egmond, H. Worldwide Regulations for Mycotoxins. Mycotoxins Food Saf. 2002, 504, 257–269. [Google Scholar]
 - Pertile, G.; Frąc, M.; Fornal, E.; Oszust, K.; Gryta, A.; Yaguchi, T. Molecular and metabolic strategies for postharvest detection of heat-resistant fungus Neosartorya fischeri and its discrimination from Aspergillus fumigatus. Postharvest Biol. Technol. 2019, 161, 111082. [Google Scholar] [CrossRef]
 - Mead, M.E.; Knowles, S.L.; Raja, H.A.; Beattie, S.R.; Kowalski, C.H.; Steenwyk, J.L.; Silva, L.P.; Chiaratto, J.; Ries, L.N.; Goldman, G.H.; et al. Characterizing the Pathogenic, Genomic, and Chemical Traits of Aspergillus fischeri, a Close Relative of the Major Human Fungal Pathogen Aspergillus fumigatus. mSphere 2019, 4, e00018-19. [Google Scholar] [CrossRef] [PubMed]
 - Guarro, J.; Kallas, E.G.; Godoy, P.; Karenina, A.; Gené, J.; Stchigel, A.; Colombo, A.L. Cerebral Aspergillosis Caused by Neosartorya hiratsukae, Brazil. Emerg. Infect. Dis. 2002, 8, 989–991. [Google Scholar] [CrossRef] [PubMed]
 - Farrell, J.J.; Kasper, D.J.; Taneja, D.; Baman, S.; O’rourke, L.M.; Lowery, K.S.; Sampath, R.; Bonomo, R.A.; Peterson, S.W. Acute Respiratory Distress caused by Neosartorya udagawae. Med. Mycol. Case Rep. 2014, 6, 1–5. [Google Scholar] [CrossRef]
 - Summerbell, R.C.; de Repentigny, L.; Chartrand, C.; St Germain, G. Graft-related endocarditis caused by Neosartorya fischeri var. spinosa. J. Clin. Microbiol. 1992, 30, 1580–1582. [Google Scholar] [CrossRef] [PubMed]
 - Han, J.I.; Na, K.J. Dermatitis Caused by Neosartorya hiratsukae Infection in a Hedgehog. J. Clin. Microbiol. 2008, 46, 3119–3123. [Google Scholar] [CrossRef]
 - Wu, L.C.; Hang, Y.D. Acid Protease Production from Neosartorya fischeri. LWT—Food Sci. Technol. 2000, 33, 44–47. [Google Scholar] [CrossRef]
 - Wang, H.; Ma, R.; Shi, P.; Huang, H.; Yang, P.; Wang, Y.; Fan, Y.; Yao, B. Insights into the substrate specificity and synergy with mannanase of family 27 α-galactosidases from Neosartorya fischeri P1. Appl. Microbiol. Biotechnol. 2015, 99, 1261–1272. [Google Scholar] [CrossRef]
 - Yi, T.; Lee, E.H.; Park, H.; Cho, K.S. Biodegradation of petroleum hydrocarbons by Neosartorya sp. BL4. J. Environ. Sci. Health A Tox Hazard Subst. Environ. Eng. 2011, 46, 1763–1768. [Google Scholar] [CrossRef]
 - Akharenegbe, P.; Chuku, A.; Mawak, J.; Sani, B.; Nsemoh, H.E.; Fadayomi, V.K. Fungal biodiversity associated with groundnuts stored in Nasarawa State. GSC Biol. Pharm. Sci. 2022, 18, 023–029. [Google Scholar] [CrossRef]
 - Lan, W.J.; Fu, S.J.; Xu, M.Y.; Liang, W.L.; Lam, C.K.; Zhong, G.H.; Xu, J.; Yang, D.P.; Li, H.J. Five New Cytotoxic Metabolites from the Marine Fungus Neosartorya pseudofischeri. Mar. Drugs 2016, 14, 18. [Google Scholar] [CrossRef]
 - Lin, S.; He, Y.; Li, F.; Yang, B.; Liu, M.; Zhang, S.; Liu, J.; Li, H.; Qi, C.; Wang, J.; et al. Structurally diverse and bioactive alkaloids from an insect-derived fungus Neosartorya fischeri. Phytochemistry 2020, 175, 112374. [Google Scholar] [CrossRef] [PubMed]
 - Kovács, R.; Nagy, F.; Tóth, Z.; Forgács, L.; Tóth, L.; Váradi, G.; Tóth, G.; Vadászi, K.; Borman, A.; Majoros, L.; et al. The Neosartorya fischeri Antifungal Protein 2 (NFAP2): A New Potential Weapon against Multidrug-Resistant Candida auris Biofilms. Int. J. Mol. Sci. 2021, 22, 771. [Google Scholar] [CrossRef] [PubMed]
 - Unthuraloet, K.; Soytong, K. Nanoparticles Constructed from Neosartorya hiratsukae to Control Drechslera oryzae Causing Brown Spot of Rice. In Proceedings of the International Seminar on Promoting Local Resources for Sustainable Agriculture and Development (ISPLRSAD 2020), Bengkulu, Indonesia, 8 October 2020. [Google Scholar]
 - Wang, Y.Y.; Zheng, S.N.; Tian, T.; Zheng, Z.Z.; Ma, L.F.; Shan, W.G.; Zhan, Z.J.; Ying, Y.M. Bioassay-Guided Isolation of Cytotoxic Steroids from Neosartorya fischeri. Chem. Nat. Compd. 2020, 56, 173–176. [Google Scholar] [CrossRef]
 - Kijjoa, A.; Santos, S.; Dethoup, T.; Manoch, L.; Almeida, A.P.; Vasconcelos, M.H.; Silva, A.; Gales, L.; Herz, W. Sartoryglabrins, Analogs of Ardeemins, from Neosartorya Glabra. Nat. Prod. Commun. 2011, 6, 807–812. [Google Scholar] [CrossRef]
 - Wang, S.L.; Yu, H.F.; Xu, Y.L.; Tian, T.; Zhan, Z.J.; Shan, W.G.; Ying, Y.M. Identification of Aszonalenin Derivatives as α-Glucosidase In-hibitors from Neosartorya fischeri NRRL 181. Chem. Nat. Compd. 2020, 56, 780–782. [Google Scholar] [CrossRef]
 - Macario, A.J.L.; Conway de Macario, E. Heat Resistance. In Encyclopedia of Stress, 2nd ed.; Academic Press: New York, NY, USA, 2007; pp. 278–283. [Google Scholar]
 - Park, H.J.; Yun, D.J. Chapter Five—New Insights into the Role of the Small Ubiquitin-like Modifier (SUMO) in Plants. In International Review of Cell and Molecular Biology; Jeon, K.W., Ed.; Academic Press: Cambridge, MA, USA, 2013; Volume 300, pp. 161–209. [Google Scholar]
 - Clarke, A.; Morris, G.J.; Fonseca, F.; Murray, B.J.; Acton, E.; Price, H.C. A Low Temperature Limit for Life on Earth. PLoS ONE 2013, 8, e66207. [Google Scholar] [CrossRef]
 - de Oliveira, G.B.; Favarin, L.; Luchese, R.H.; McIntosh, D. Psychrotrophic bacteria in milk: How much do we really know? Braz. J. Microbiol. 2015, 46, 313–321. [Google Scholar] [CrossRef]
 - Schiraldi, C.; De Rosa, M. Mesophilic Organisms. In Encyclopedia of Membranes; Springer: Berlin/Heidelberg, Germany, 2016; pp. 1–2. [Google Scholar]
 - Mendonca, A.; Thomas-Popo, E.; Gordon, A. Microbiological considerations in food safety and quality systems implementation. In Food Safety and Quality Systems in Developing Countries; Academic Press: Cambridge, MA, USA, 2020; pp. 185–260. [Google Scholar]
 - Ianutsevich, E.A.; Danilova, O.A.; Groza, N.V.; Kotlova, E.R.; Tereshina, V.M. Heat shock response of thermophilic fungi: Membrane lipids and soluble carbohydrates under elevated temperatures. Microbiology 2016, 162, 989–999. [Google Scholar] [CrossRef]
 - Manners, J.; Craven, H. MILK | Processing of Liquid Milk. In Encyclopedia of Food Sciences and Nutrition, 2nd ed.; Caballero, B., Ed.; Academic Press: Oxford, UK, 2003; pp. 3951–3957. [Google Scholar]
 - Tiwari, S.; Thakur, R.; Shankar, J. Role of Heat-Shock Proteins in Cellular Function and in the Biology of Fungi. Biotechnol. Res. Int. 2015, 2015, 132635. [Google Scholar] [CrossRef]
 - Deák, T. Food Technologies: Pasteurization. In Encyclopedia of Food Safety; Motarjemi, Y., Ed.; Academic Press: Waltham, MA, USA, 2014; pp. 219–224, 245–252. [Google Scholar]
 - Alvarenga, V.O.; Gonzales-Barron, U.; do Prado Silva, L.; Cadavez, V.; Sant’Ana, A.S. Using extended Bigelow meta-regressions for modelling the effects of temperature, pH, °Brix on the inactivation of heat resistant moulds. Int. J. Food Microbiol. 2021, 338, 108985. [Google Scholar] [CrossRef]
 - Kosters, P.S.R.; Waldron, K.W. Production of high-value functional vegetable juices from food co-products. In Handbook of Waste Management and Co-Product Recovery in Food Processing; Waldron, K., Ed.; Woodhead Publishing: Sawston, UK, 2009; pp. 376–390. [Google Scholar]
 - Lane Paixão dos Santos, J.; Samapundo, S.; Van Impe, J.; Sant’Ana, A.S.; Devlieghere, F. Effect of sugar concentration (°Brix) and storage temperature on the time to visible growth of individual ascospores of six heat-resistant moulds isolated from fruit products. Food Control 2020, 108, 106880. [Google Scholar] [CrossRef]
 - Ravishankar, S.; Juneja, V.K. PRESERVATIVES | Traditional Preservatives—Sodium Chloride. In Encyclopedia of Food Microbiology, 2nd ed.; Academic Press: Oxford, UK, 2014; pp. 131–136. [Google Scholar]
 - Lindquist, S.; Craig, E.A. The heat-shock proteins. Annu. Rev. Genet. 1988, 22, 631–677. [Google Scholar] [CrossRef]
 - Lamoth, F.; Juvvadi, P.R.; Steinbach, W.J. Heat shock protein 90 (Hsp90): A novel antifungal target against Aspergillus fumigatus. Crit. Rev. Microbiol. 2016, 42, 310–321. [Google Scholar]
 - Lamoth, F.; Juvvadi, P.R.; Fortwendel, J.R.; Steinbach, W.J. Heat shock protein 90 is required for conidiation and cell wall integrity in Aspergillus fumigatus. Eukaryot. Cell 2012, 11, 1324–1332. [Google Scholar] [CrossRef] [PubMed]
 - Tereshina, V.M. Thermotolerance in Fungi: The Role of Heat Shock Proteins and Trehalose. Microbiology 2005, 74, 247–257. [Google Scholar] [CrossRef]
 - Wyatt, T.T.; van Leeuwen, M.R.; Golovina, E.A.; Hoekstra, F.A.; Kuenster, E.J.; Palumbo, E.A.; Snyder, N.L.; Visagie, C.; Verkennis, A.; Hallsworth, J.E.; et al. Functionality and prevalence of trehalose-based oligosaccharides as novel compatible solutes in ascospores of Neosartorya fischeri (Aspergillus fischeri) and other fungi. Environ. Microbiol. 2015, 17, 395–411. [Google Scholar] [CrossRef]
 - Kuenstner, E.; Palumbo, E.; Levine, J.; Snyder, N. Synthesis of isobemisiose, neosartose, and fischerose: Three α-1,6-linked treha-lose-based oligosaccharides identified from Neosartorya fischeri. RSC Adv. 2020, 10, 22726–22729. [Google Scholar] [CrossRef]
 - Yang, X.; Ma, R.; Shi, P.; Huang, H.; Bai, Y.; Wang, Y.; Yang, P.; Fan, Y.; Yao, B. Molecular Characterization of a Highly-Active Thermophilic β-Glucosidase from Neosartorya fischeri P1 and Its Application in the Hydrolysis of Soybean Isoflavone Glycosides. PLoS ONE 2014, 9, e106785. [Google Scholar] [CrossRef] [PubMed]
 - Hang, Y.D.; Woodams, E.E. Characterization of Glucoamylase from Neosartorya fischeri. Lwt—Food Sci. Technol. 1993, 26, 483–484. [Google Scholar] [CrossRef]
 - Vega, F.E.; Simpkins, A.; Aime, M.C.; Posada, F.; Peterson, S.W.; Rehner, S.A.; Infante, F.; Castillo, A.; Arnold, A.E. Fungal endophyte diversity in coffee plants from Colombia, Hawai’i, Mexico and Puerto Rico. Fungal Ecol. 2010, 3, 122–138. [Google Scholar] [CrossRef]
 - Evelyn Kim, H.J.; Silva, F.V.M. Modeling the inactivation of Neosartorya fischeri ascospores in apple juice by high pressure, power ultrasound and thermal processing. Food Control 2016, 59, 530–537. [Google Scholar] [CrossRef]
 - Yıldırım, K.F.; Ulusoy, H.B.; Hamed, S.N. Heat-resistant moulds: Assessment, prevention and their conse-quences for food safety and public health. Czech J. Food Sci. 2022, 40, 273–280. [Google Scholar] [CrossRef]
 - Awuah, R.T.; Adzim, E. Etiological and epidemiological studies on the red leaf disease of pineapple in Ghana. Afr. Crop Sci. J. 2004, 12, 153–162. [Google Scholar] [CrossRef]
 - Shan, T.; Sun, W.; Lou, J.; Gao, S.; Mou, Y.; Zhou, L. Antibacterial activity of the endophytic fungi from medicinal herb, Macleaya cordata. Afr. J. Biotechnol. 2012, 11, 4354–4359. [Google Scholar]
 - Hamayun, M.; Khan, S.A.; Khan, A.L.; Ahmad, N.; Nawaz, Y.; Sher, H.; Lee, I.-J. Gibberellin producing Neosartorya sp. CC8 reprograms Chinese cabbage to higher growth. Sci. Hortic. 2011, 129, 347–352. [Google Scholar] [CrossRef]
 - Punyanobpharat, A.; Soytong, K.; Poeaim, S. Effective of Neosartorya and Talaromyces to control Alternaria brassicicola causing leaf spot of kale. Int. J. Agric. Technol. 2018, 14, 1709–1718. [Google Scholar]
 - Likar, M.; Grašič, M.; Stres, B.; Regvar, M.; Gaberščik, A. Original Leaf Colonisers Shape Fungal Decomposer Communities of Phragmites australis in Intermittent Habitats. J. Fungi 2022, 8, 284. [Google Scholar] [CrossRef]
 - Seufert, V.; Ramankutty, N.; Mayerhofer, T. What is this thing called organic?—How organic farming is codified in regulations. Food Policy 2017, 68, 10–20. [Google Scholar] [CrossRef]
 - Litterick, A.M.; Watson, C.A. Organic Farming. In Encyclopedia of Applied Plant Sciences, 2nd ed.; Academic Press: Oxford, UK, 2017; pp. 311–317. [Google Scholar]
 - Crinnion, W.J. Organic foods contain higher levels of certain nutrients, lower levels of pesticides, and may provide health benefits for the consumer. Altern. Med. Rev. 2010, 15, 4–12. [Google Scholar]
 - Pandey, J.; Pandey, U. Accumulation of heavy metals in dietary vegetables and cultivated soil horizon in organic farming system in relation to atmospheric deposition in a seasonally dry tropical region of India. Environ. Monit. Assess. 2009, 148, 61–74. [Google Scholar] [CrossRef] [PubMed]
 - Lockeretz, W. Organic Farming: An International History; CABI: Wallingford, UK, 2007. [Google Scholar]
 - Wrzesińska-Kowal, J.; Drabarczyk, K. Food production in Poland, compared to selected European Union Member States. Sci. J. Wars. Univ. Life Sci.-SGGW Probl. World Agric. 2014, 14, 205–214. [Google Scholar]
 - Rossi, R. The EU Fruit and Vegetable Sector. Main Features, Challenges and Prospects; European Parliamentary Research Service: Brussels, Belgium, 2019; pp. 1–12. [Google Scholar]
 - Jess, S.; Kildea, S.; Moody, A.; Rennick, G.; Murchie, A.K.; Cooke, L.R. European Union policy on pesticides: Implications for agri-culture in Ireland. Pest Manag. Sci. 2014, 70, 1646–1654. [Google Scholar] [CrossRef]
 - Shucksmith, M.; Thomson, K.J.; Roberts, D. The CAP and the Regions: The Territorial Impact of the Common Agricultural Policy; CABI Publishing: Wallingford, UK, 2005. [Google Scholar]
 - Ibeawuchi, I.I.; Okoli, N.A.; Alagba, R.A.; Ofor, M.O.; Emma-Okafor, L.C.; Peter-Onoh, C.A.; Obiefuna, J.C. Fruit and Vegetable Crop Production in Nigeria: The Gains, Challenges and The Way Forward. J. Biol. Agric. Healthc. 2015, 5, 194–209. [Google Scholar]
 - Retamales, J.B. World temperate fruit production: Characteristics and challenges. Rev. Bras. Frutic. 2011, 33, 121–130. [Google Scholar] [CrossRef]
 - Perricone, M.; Bevilacqua, A.; Altieri, C.; Sinigaglia, M.; Corbo, M.R. Challenges for the Production of Probiotic Fruit Juices. Beverages 2015, 1, 95–103. [Google Scholar] [CrossRef]
 - Sharma, R.R.; Singh, D.; Singh, R. Biological control of postharvest diseases of fruits and vegetables by microbial antagonists: A review. Biol. Control 2009, 50, 205–221. [Google Scholar] [CrossRef]
 - Belabbes, R.; Dib, M.E.A.; Djabou, N.; Ilias, F.; Tabti, B.; Costa, J.; Muselli, A. Chemical Variability, Antioxidant and Antifungal Activities of Essential Oils and Hydrosol Extract of Calendula arvensis L. from Western Algeria. Chem. Biodivers. 2017, 14, e1600482. [Google Scholar] [CrossRef] [PubMed]
 - Jayan, L.; Priyadharsini, N.; Ramya, R.; Rajkumar, K. Evaluation of antifungal activity of mint, pomegranate and coriander on fluconazole-resistant Candida glabrata. J. Oral Maxillofac. Pathol. 2020, 24, 517–522. [Google Scholar]
 - Behmanesh, F.; Pasha, H.; Sefidgar, A.A.; Taghizadeh, M.; Moghadamnia, A.A.; Rad, H.A.; Shirkhani, L. Antifungal Effect of Lavender Essential Oil (Lavandula angustifolia) and Clotrimazole on Candida albicans: An In Vitro Study. Scientifica 2015, 2015, 261397. [Google Scholar] [CrossRef]
 - Ale, A.; Bacchetta, C.; Cazenave, J. Feb—Fresenius Environmental Bulletin. Fresenius Environ. Bull. 2017, 26, 4082–4087. [Google Scholar]
 - Salomão, B.; Slongo, A.P.; Aragao, G. Heat resistance of Neosartorya fischeri in various juices. LWT—Food Sci. Technol. 2007, 40, 676–680. [Google Scholar] [CrossRef]
 - Makovitzki, A.; Shai, Y. pH-Dependent Antifungal Lipopeptides and Their Plausible Mode of Action. Biochemistry 2005, 44, 9775–9784. [Google Scholar] [CrossRef]
 - Fang, S.W.; Li, C.F.; Shih, D.Y.C. Antifungal Activity of Chitosan and Its Preservative Effect on Low-Sugar Candied Kumquat. J. Food Prot. 1994, 57, 136–140. [Google Scholar] [CrossRef]
 - Kondratenko, V.; Trishkaneva, M.; Levshenko, M.; Pozdnyakova, T.; Kolokolova, A. Study of thermal stability of ascospores As-pergillus (Neosartorya) fischeri depending on the concentration of soluble solids in apple juice. Proc. Voronezh State Univ. Eng. Technol. 2019, 81, 91–98. [Google Scholar] [CrossRef]
 - Menezes, N.M.C.; Tremarin, A.; Junior, A.F.; de Aragão, G.M.F. Effect of soluble solids concentration on Neosartorya fischeri inac-tivation using UV-C light. Int. J. Food Microbiol. 2019, 296, 43–47. [Google Scholar] [CrossRef] [PubMed]
 - Uttara, V.; Ankulkar, R.; Ahmed, Z.; Mirza, Y. Synergistic Inhibitory Activity of Bacillomycin D, Surfactin and Nisin against Thermoascus crustaceus, Neosartorya hiratsukae and Bacillus subtilis, Responsible for Cardboard Spoilage. J. Pure Appl. Microbiol. 2020, 14, 2555–2567. [Google Scholar]
 - Khalid, M.A.; Niaz, B.; Saeed, F.; Afzaal, M.; Islam, F.; Hussain, M.; Mahwish Khalid, H.M.S.; Siddeeg, A.; Al-Farga, A. Edible coatings for enhancing safety and quality attributes of fresh produce: A comprehensive review. Int. J. Food Prop. 2022, 25, 1817–1847. [Google Scholar] [CrossRef]
 - Salsabiela, S.; Sukma Sekarina, A.S.; Bagus, H.; Audiensi, A.; Azizah, F.; Heristika, W.; Manikharda Susanto, E.; Munawaroh, H.S.H.; Show, P.L.; Ningrum, A. Development of Edible Coating from Gelatin Composites with the Addition of Black Tea Extract (Camellia sinensis) on Minimally Processed Watermelon (Citrullus lanatus). Polymers 2022, 14, 2628. [Google Scholar] [CrossRef]
 - Vieira, T.M.; Moldão-Martins, M.; Alves, V.D. Composite Coatings of Chitosan and Alginate Emulsions with Olive Oil to Enhance Postharvest Quality and Shelf Life of Fresh Figs (Ficus carica L. cv. ‘Pingo De Mel’). Foods 2021, 10, 718. [Google Scholar] [CrossRef]
 - Szymańska-Chargot, M.; Chylińska, M.; Pertile, G.; Pieczywek, P.M.; Cieślak, K.J.; Zdunek, A.; Frąc, M. Influence of chitosan addition on the mechanical and antibacterial properties of carrot cellulose nanofiber film. Cellulose 2019, 26, 9613–9629. [Google Scholar] [CrossRef]

| Species Name | Synonymous Species | High Similarity or Identical Features | Status | Ref. | 
|---|---|---|---|---|
| Neosartorya otanii | N. fennelliae | Identical β-tubulin gene sequences, no differences in ascospores | Mating experiments needed for proof | [21] | 
| N. spinosa | N. botucatensis, N. paulistensis, N. takaki | Circular arrangements on the convex walls of ascospores | Accepted | [22] | 
| Neosartorya primulina | N. quadricincta | Nearly identical gene sequences for β-tubulin, calmodulin and actin, morphology, ascospore ornamentation, restricted growth on Czapek agar | Accepted | [22] | 
| Neosartorya delicata | N. tatenoi | Identical ascospore morphology, nearly identical gene sequences for β-tubulin, calmodulin and actin | Accepted | [22] | 
Disclaimer/Publisher’s Note: The statements, opinions and data contained in all publications are solely those of the individual author(s) and contributor(s) and not of MDPI and/or the editor(s). MDPI and/or the editor(s) disclaim responsibility for any injury to people or property resulting from any ideas, methods, instructions or products referred to in the content.  | 
© 2023 by the authors. Licensee MDPI, Basel, Switzerland. This article is an open access article distributed under the terms and conditions of the Creative Commons Attribution (CC BY) license (https://creativecommons.org/licenses/by/4.0/).
Share and Cite
Maj, W.; Pertile, G.; Frąc, M. Soil-Borne Neosartorya spp.: A Heat-Resistant Fungal Threat to Horticulture and Food Production—An Important Component of the Root-Associated Microbial Community. Int. J. Mol. Sci. 2023, 24, 1543. https://doi.org/10.3390/ijms24021543
Maj W, Pertile G, Frąc M. Soil-Borne Neosartorya spp.: A Heat-Resistant Fungal Threat to Horticulture and Food Production—An Important Component of the Root-Associated Microbial Community. International Journal of Molecular Sciences. 2023; 24(2):1543. https://doi.org/10.3390/ijms24021543
Chicago/Turabian StyleMaj, Wiktoria, Giorgia Pertile, and Magdalena Frąc. 2023. "Soil-Borne Neosartorya spp.: A Heat-Resistant Fungal Threat to Horticulture and Food Production—An Important Component of the Root-Associated Microbial Community" International Journal of Molecular Sciences 24, no. 2: 1543. https://doi.org/10.3390/ijms24021543
APA StyleMaj, W., Pertile, G., & Frąc, M. (2023). Soil-Borne Neosartorya spp.: A Heat-Resistant Fungal Threat to Horticulture and Food Production—An Important Component of the Root-Associated Microbial Community. International Journal of Molecular Sciences, 24(2), 1543. https://doi.org/10.3390/ijms24021543
        
